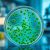
Choroba cholera: objawy, przyczyny i metody leczenia

Zioła w kosmetyce – jak wykorzystać ich naturalne właściwości?
Zioła od wieków fascynują ludzi nie tylko swoją różnorodnością, ale także niezwykłymi właściwościami, które znajdują zastosowanie w różnych dziedzinach życia. W kosmetologii, zioła stają się nieodłącznym elementem, który wnosi do produktów pielęgnacyjnych naturalność i skuteczność. Około 75% surowców zielarskich wykorzystywanych w przemyśle kosmetycznym pochodzi z upraw, co podkreśla ich istotną rolę w produkcji kosmetyków. Dzięki swoim właściwościom nawilżającym, przeciwzapalnym i łagodzącym, zioła nie tylko poprawiają kondycję skóry i włosów, ale również stają się alternatywą dla syntetycznych składników, które mogą powodować alergie. W dobie rosnącej popularności kosmetyków naturalnych, warto przyjrzeć się najpopularniejszym ziołom oraz ich zastosowaniom w codziennej pielęgnacji.
Zioła w kosmetyce – ich znaczenie i zastosowanie
Zioła pełnią niezwykle istotną rolę w świecie kosmetyków. Stanowią one bogate źródło naturalnych substancji aktywnych, które mają pozytywny wpływ na zdrowie naszej skóry oraz włosów. W kosmetykach roślinnych możemy znaleźć wiele cennych składników, takich jak flawonoidy, witamina czy minerały, które znacząco poprawiają kondycję zarówno skóry, jak i włosów. W ostatnich latach rośnie zainteresowanie kosmetykami opartymi na naturalnych składnikach; coraz więcej osób decyduje się unikać syntetycznych dodatków.
Zioła stosowane w kosmetykach dostępne są w różnych postaciach – od olejków eterycznych po ekstrakty czy suszone rośliny. Ich właściwości pielęgnacyjne obejmują między innymi:
- działanie nawilżające,
- działanie przeciwzapalne,
- działanie antyoksydacyjne.
Na przykład rumianek skutecznie łagodzi podrażnienia, pokrzywa wspomaga wzrost włosów, a szałwia reguluje wydzielanie sebum.
Co ciekawe, aż 75% surowców zielarskich wykorzystywanych przez przemysł farmaceutyczny oraz kosmetyczny pochodzi z upraw. To dowodzi ogromnego znaczenia ziół w produkcji kosmetyków i ich wpływu na rozwój tej branży. W miarę jak coraz więcej konsumentów poszukuje naturalnych rozwiązań do swoich problemów skórnych i estetycznych, rynek kosmetyków ziołowych dynamicznie się rozwija.
Wprowadzenie ziół do produktów kosmetycznych nie tylko wzbogaca je o wartościowe składniki odżywcze, ale również sprzyja ochronie środowiska poprzez promowanie biodegradowalnych oraz ekologicznych rozwiązań w branży urodowej.
Właściwości pielęgnacyjne ziół w kosmetykach
Zioła w kosmetykach oferują szereg cennych właściwości, które korzystnie wpływają na zdrowie oraz wygląd naszej skóry i włosów. Dzięki obecności aktywnych substancji, takich jak flawonoidy, garbniki czy olejki eteryczne, zioła skutecznie nawilżają skórę, co jest kluczowe dla utrzymania odpowiedniego poziomu wilgoci.
Ich działanie przeciwzapalne sprawia, że stanowią doskonały wybór dla osób borykających się z problemami skórnymi, takimi jak:
- trądzik,
- podrażnienia.
Zioła łagodzą stany zapalne i przyspieszają proces gojenia ran. Dodatkowo ich regeneracyjne właściwości wspierają odbudowę komórek skóry oraz poprawiają jej elastyczność.
Kosmetyki oparte na ziołach mają mniejsze ryzyko wywoływania alergii w porównaniu do syntetycznych produktów, przez co są polecane osobom z wrażliwą cerą lub skłonnościami do reakcji alergicznych. Zioła nie tylko korzystnie wpływają na zdrowie skóry twarzy, ale także wzmacniają włosy i nadają im piękny blask.
Warto również zauważyć, że stosowanie kosmetyków zawierających zioła to nie tylko kwestia pielęgnacji. To także powrót do natury oraz wybór bardziej ekologicznych rozwiązań w codziennej rutynie urodowej.
Jak zioła wpływają na skórę i włosy?
Zioła odgrywają kluczową rolę w pielęgnacji skóry i włosów, oferując szereg cennych korzyści dzięki swoim unikalnym właściwościom. W kosmetykach ziołowych często występują w postaci olejków eterycznych, hydrolatów czy ekstraktów, co sprawia, że ich działanie jest niezwykle efektywne.
W przypadku pielęgnacji skóry szczególnie wartościowe są rośliny takie jak:
- rumianek, znany ze swoich właściwości przeciwzapalnych oraz łagodzących,
- nagietek, który pomaga osobom z cerą podatną na podrażnienia,
- fiołek trójbarwny, który pomaga w walce z trądzikiem,
- czystek, który oczyszcza skórę i redukuje nadmierne przetłuszczanie.
Jeśli chodzi o włosy, wyróżniają się:
- pokrzywa, stymulująca wzrost włosów oraz wzmacniająca cebulki,
- szałwia, która przynosi ulgę skórze głowy i poprawia kondycję fryzury.
Odżywki zawierające te składniki przynoszą ulgę skórze głowy i przyczyniają się do poprawy kondycji fryzury. Szampony wzbogacone o zioła skutecznie oczyszczają skalp oraz pomagają radzić sobie z problemami takimi jak łupież czy nadmierne przetłuszczanie.
Systematyczne korzystanie z produktów opartych na ziołach może znacząco wpłynąć na zdrowie oraz atrakcyjny wygląd zarówno skóry, jak i włosów. Coraz większą popularnością cieszą się kosmetyki DIY, które pozwalają dostosować kuracje do indywidualnych potrzeb cery oraz struktury włosów.
Jakie są najpopularniejsze zioła stosowane w kosmetykach?
- Aloes słynie z wyjątkowych właściwości nawilżających oraz zdolności łagodzenia podrażnień skóry,
- Kurkuma ma działanie przeciwzapalne i dodaje skórze blasku,
- Rumianek jest ceniony za swoje kojące i przeciwzapalne efekty, co czyni go doskonałym wyborem dla osób z wrażliwą cerą,
- Szałwia wyróżnia się działaniem antyseptycznym i pomaga regulować wydzielanie sebum, co jest korzystne dla cery tłustej,
- Nagietek działa kojąco i wspiera regenerację tkanek,
- Pokrzywa tonizuje skórę i wzmacnia włosy dzięki bogactwu witamin oraz minerałów,
- Dziurawiec wykazuje działanie przeciwzapalne i wspomaga proces gojenia ran.
Zioła te można spotkać w różnych formach: jako ekstrakty, olejki eteryczne czy suszone liście. Dzięki temu znalazły swoje miejsce w kosmetykach do pielęgnacji zarówno skóry, jak i włosów.
Jakie są przepisy na kosmetyki DIY z wykorzystaniem ziół?
Przepisy na kosmetyki DIY z ziołami są proste i dostępne dla każdego, kto pragnie zadbać o naturalną pielęgnację. Oto kilka inspirujących receptur, które warto wypróbować:
- Regenerująca kąpiel z tymiankiem: wrzuć do wanny garść suszonego tymianku oraz kilka kropli ulubionego olejku eterycznego. Taka kąpiel nie tylko relaksuje, ale również łagodzi skórę.
- Nawilżająca maseczka z ogórkiem, miodem i szałwią: zmiksuj pół ogórka, a następnie dodaj łyżkę miodu oraz świeżej szałwii. Nałóż mieszankę na twarz na 15 minut, a później spłucz ciepłą wodą.
- Odświeżający tonik z nagietkiem: przygotuj napar z nagietka, używając 1 łyżki suszonych kwiatów na szklankę wrzątku. Po ostudzeniu stosuj go jako tonik do twarzy.
- Przeciwtrądzikowy tonik z tymiankiem: zaparz mocny napar z tymianku (2 łyżki suszu na szklankę wrzątku) i aplikuj miejscowo na zmiany trądzikowe.
- Nawilżający peeling do twarzy z różą i lawendą: połącz mieloną kawę, brązowy cukier oraz olej kokosowy w równych proporcjach, a następnie dodaj kilka kropli olejku różanego i lawendowego.
- Ziołowy peeling do ciała: wymieszaj sól morską lub cukier ze zmielonymi liśćmi mięty oraz oliwą z oliwek dla delikatnego masażu całego ciała.
- Płukanka ziołowa na porost włosów z pokrzywą: przygotuj napar z pokrzywy (2-3 łyżki suszu na litr wrzątku) i używaj go jako ostatniego płukania po myciu włosów.
Te przepisy dowodzą, jak łatwo można wykorzystać właściwości roślin w domowych kosmetykach typu DIY. Dzięki nim Twoja skóra i włosy mogą korzystać ze zdrowotnych darów natury!
Materiał przygotowany dzięki wsparciu zioła w kosmetyce.

Najnowsze komentarze